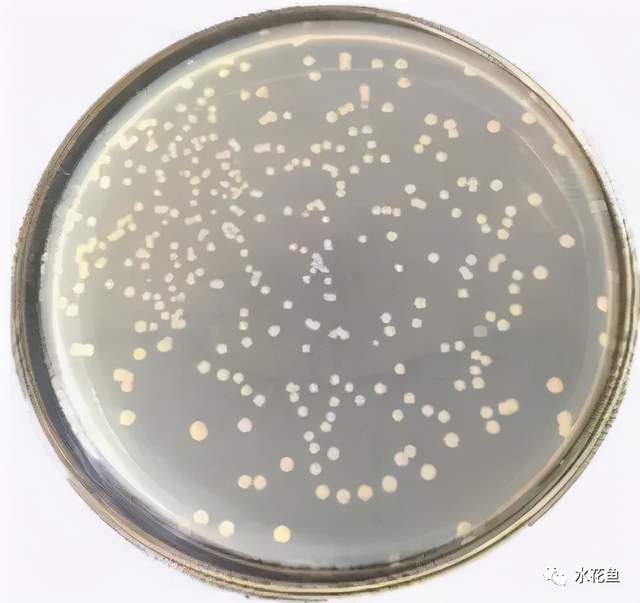
鱼类皮肤功能_痘疮病_鱼类皮肤病种类及危害
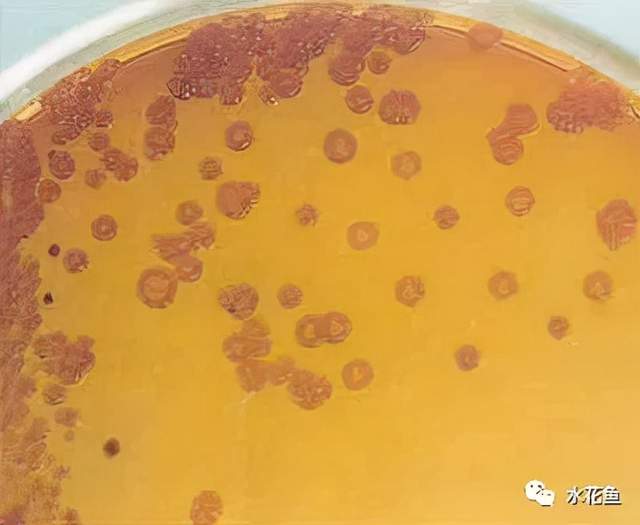
鱼类皮肤病种类及危害_鱼类皮肤功能_痘疮病

鱼类皮肤病种类及其皮肤溃烂病的探讨与防治
清楚农业生产的艰辛,合力促进水产领域兴旺。绝不虚假宣传,不夸大其词,不制造噱头,不博取眼球。以生产者的视角,助你在短时间内品尝到优质产品!
鱼类的体表由表皮和真皮构成,还带有一种特殊腺体,这种腺体能分泌许多粘液,让体表变得滑润,同时也能在鱼体外部形成一道物理防护层,帮助鱼体抵御病原体的侵害。

1 鱼类健康与鱼类皮肤
1. 鱼类皮肤功能
鱼类的体表覆盖有黏液层,这层黏液是多种生物活性物质的载体,包括免疫球蛋白、抗菌肽、溶菌酶、凝集素、白细胞介素1L-1以及蛋白酶等,同时它也是抵御病原菌附着和侵入的天然保护层。一旦鱼类的皮肤出现破损,就很容易受到细菌感染,从而引发死亡。鱼类的皮肤破损现象较为普遍,多由体外寄生虫附着或鱼体因外力作用受损,进而引发细菌、真菌等病原体的继发性感染,导致皮肤发炎。炎症部位会逐渐坏死,组织坏死脱落,形成缺损。根据缺损的深度不同,浅表的称为渗出性损伤开yun体育app官网网页登录入口,深层的则称为溃疡面。

倘若致病微生物得以突破这道屏障,那么细胞免疫与体液免疫便会随之启动,用以遏制致病微生物的持续侵害。
要是病原体攻击性很强,鱼儿的防御能力又比较弱,这些病原体就会在鱼的体表扎根、发育和扩散,导致体表出现流血、结痂、破口、破损等多种病症表现。
鱼类皮肤具有良好的免疫防御功能。
2.鱼类健康与皮肤关系
鱼类的表皮细胞里有很多分泌黏液的腺体,这些黏液均匀涂抹在鱼身上,形成了鱼与外部环境直接接触的屏障kaiyun.ccm,对鱼类的整个生命历程都极为关键。
鱼类的表皮是导致有害微生物和寄生虫感染的常见门户,表皮是鱼类关键的防御机制,由于它们频繁接触多种微生物,涵盖致病体和机会致病体,以及寄生虫,这些生物体可能附着在表皮上,进而危害鱼体健康。

2 鱼类皮肤病的种类及危害
导致鱼类皮肤出现病变的生物因素主要有病毒、细菌、真菌、寄生虫以及单胞藻类等,这些生物因素一旦侵入鱼体皮肤,就会对皮肤组织造成严重损伤,部分病症还会引发鱼类大量死亡,从而对水产养殖产业带来显著的经济损失。
1.病毒性皮肤病
鱼类容易受到病毒性皮肤病的侵袭,其中危害性比较突出的包括草鱼出血病,还有病毒性出血性败血症,此外还有鲤春病毒血症,锦鲤疱疹病毒,上皮囊肿病,以及鲤痘疮病,另外还有流行性造血器官坏死病,最后是淋巴囊肿病。

(痘疮病)
病毒性皮肤病一旦发作,危害极大。其中鲤春病毒血症属于农业部划定的一类传染病,草鱼出血病、锦鲤疱疹病毒、传染性造血器官坏死病、病毒性出血性败血症则被归为二类传染病。
2.细菌性皮肤病的病原
(1)链球菌属
链球菌存在于海水养殖的鰤鱼、牙鲆、真鲷、黑鲷、红鳍东方鲀之中,也出现在半咸水及淡水养殖的鳗鲡、香鱼、大麻哈鱼、罗非鱼之中。

这种细菌主要导致鱼类出现败血症,并伴随全身性出血现象。患病鱼体色会变深发黑,嘴巴部位呈现红色,体表分泌的粘液明显增多,导致它们丧失进食欲望,常常静止在水底,或者脱离群体在水面上独自游弋,有时还会进行旋转式游动然后沉入水底。它们的眼睛会向外凸出,眼周区域出现红肿,鳃盖内侧也会发生出血、红肿或严重出血的情况。当水温较低时,除了上述症状,所有鱼鳍都会发红、红肿或出现破损,体表局部尤其是尾柄部位常常发生溃烂,甚至带有脓血形成的疮痂。
链球菌导致鱼的胃垂、肝脏、脾脏、肾脏或肠道出现斑点状出血现象。肝脏由于出血及脂肪发生病变,颜色变得苍白,甚至组织结构遭到破坏。肾脏呈现肿胀状态,并伴有坏死情况。中等肠段的黏膜下层受到损伤,从而引发肠炎。在肠绒毛的根部,通过革兰氏染色能够观察到成团的细菌菌落聚集。
(2)弧菌属
主要侵袭海水中的鱼类,其表现状况因涉及到的病原体有所区别,并且会根据鱼种的不同而有所变化。所有受感染的鱼都呈现出体表皮肤破损的症状。

发病初始阶段,身体颜色常呈现片状变浅,吃食减少,行动迟缓地漂在水上,偶尔会转圈游动;病情进一步时,鱼鳍根部和身体部分会发红或者有斑点式出血,随着病症加剧,受影响的部位会形成出血性破损,部分鱼鳞会掉落,嘴尖和鱼鳍末端会腐烂,眼睛内部有出血现象,肛门会红肿变大,并常有黄色分泌物渗出。
(3)气单胞菌属
这种细菌会导致鳗鱼出现赤鳍症状,鲤鱼和金鱼患上竖鳞症,鲢鳙发生打印病,青草鱼患上肠道细菌感染,青鱼得疥疮症,蛙类出现红腿问题,鲟鱼罹患嗜水气单胞菌症。
温和气单胞菌能导致团头鲂、斑点叉尾鮰、草鱼、鲢、鳙等淡水鱼类发生出血性败血症,还会引发异育银鲫的溶血性腹水病,并且能引起鲤鱼、鳖、蛙的溃疡病。

这两种气单胞菌能够导致细菌性败血症的发生。患病鱼类的全身表皮会出现红肿和出血现象,其上下颌、口腔、鳃盖、眼睛、鳍条以及鱼体两侧都可能出现红肿和出血,其中腹部和头部的红肿出血最为明显,严重时肌肉也会出现红肿和出血。眼球会向外突出,肛门会变得红肿,腹部会膨胀起来。

豚鼠气单胞菌可引起鱼类竖鳞病、打印病、疥疮病。
鱼得了竖鳞病,它的鳞片全都竖起来,向外鼓胀,样子像“松球”,鳞片下面有液体渗出。

(竖鳞病)
鱼儿的身体两侧,或者尾巴的根部,皮肤上会出现圆形或者椭圆形的红色斑点,这些斑点看起来像是红色的印记,像是被盖章一样,病情如果比较严重的话,这些斑点所在的地方,肌肉会烂掉,形成溃疡,如果病情非常严重的话,甚至能看到骨头或者内脏。

疥疮病:鱼身体某些部位皮肤上长出脓包,随着病情加重,患处会化脓,向外鼓起,用手触摸感觉发软并且肿胀。

(疥疮病)
鲑鳟鱼类的疥疮病主要是由杀鲑气单胞菌引发的,这种病症在褐鳟、红大马哈鱼、马苏大麻哈鱼、布努克鳟身上表现得最为明显。该病原体通过皮肤进入鱼体,并在躯干的肌肉部分造成微小的感染区域。随着细菌的繁殖,肌肉组织会逐渐溶解并坏死,同时伴随出血、浆液渗出以及炎症细胞浸润的现象。受影响的组织会变得柔软,向外凸起,最终形成被称为“疥疮”的病变。有时皮肤也会因此溃烂,产生“溃疡”。
这三种细菌联合侵染能导致鱼儿出现体表破损和尾部腐烂的症状。

现在导致鱼类表皮破损的微生物很多是革兰氏阴性菌,包括假单胞菌、气单胞菌、爱德华氏菌、弧菌等种类,其中较为普遍的是草鱼出现的赤皮病、鲢鳙发生的打印病、黄颡鱼患上的爆头病。而真菌则多为丝囊霉属的真菌,典型病例是乌鳢感染上的流行性溃疡综合症。

鱼皮破损时,放大镜下能看见,受感染鱼体的肌肉组织出现损伤、崩解,纤维间隙变得不一样宽,局部有液体渗出,并且能看到淋巴细胞和巨噬细胞这类发炎细胞聚集在那里

病势加剧时,细菌不断滋生,其代谢产物引发毒性反应,导致鱼体内部器官显著受损,肝脏呈现肿胀,颜色变浅,伴有土黄色浑浊斑点,肝细胞出现颗粒状及泡状变化,肾脏与脾脏也发生轻重不一的肿胀和变黑现象,肠道壁变红,内壁有出血现象,肠腔内可见黄绿色脓性分泌物,表现出类似全身性感染的征象,因而造成大批死亡。
(4)假单胞菌属
荧光假单胞菌通过伤口进入皮肤内部,导致体表皮肤部分或全部出现出血、炎症反应,伴有鳞屑脱落、皮肤破损以及溃疡形成。
病变常出现在鱼体两侧、腹部以及鳍条和鳃区,鳍条间隙的黏膜组织会出现溃烂现象,形成所谓的“蛀鳍”症状,同时肌肉组织会呈现明显的红肿状态,表现为“赤皮”病症。此外,这种病症还可能导致鱼体表面覆盖一层乳白色黏液,例如在鲤、江团和鲟鱼身上出现的“白云病”现象。

(蛀鳍)
这种细菌主要危害鳗鱼和香鱼,泥鳅也容易感染,表现为血管出现炎症反应,进而导致液体渗漏或血管损伤,在鱼体表面广泛分布,形成散在或聚集性的出血点,所以得名“红点病”。

出血位置多见于患鱼的下巴部位、鳃盖处、前肢根部、身体前侧、背部或排泄口附近的表皮。另外,腹腔膜以及内部器官也可能出现出血或血肿现象。
(5)柱状黄杆菌
这种病原体会在鱼的鳍部、嘴部、鳃片边缘以及身体表面出现微小的黄白色疙瘩,这些疙瘩会慢慢变大,并且使病变区域附近的皮肤红肿。

鱼体表面受损,皮肤上的鳞片会掉落,进而产生疮口。病变首先出现在鳍的末端,导致鳍条逐渐腐坏开元棋官方正版下载,鳃部的粘液分泌量增多,鳃丝最终变成类似扫帚的形态。然而,患有此症的鱼,其内部器官通常仍保持正常状态。
(6)星型诺卡菌
多在身体皮下和肌肉区域生成脓包,表面可见明显隆起,形成大小不一、形态各异的疙瘩或脓包。
脓疮被切开时会冒出乳白色或略带血色的粘稠液体,病变区域常布满叠起的纤维母细胞。此类结节经常出现在心脏、脾脏、肾脏以及膀胱等器官,受损部位普遍伴随炎症现象。
3.真菌性皮肤病
水霉和肤霉通过皮肤破损处进入鱼体,依附在鱼体表面生长,在病症初始阶段,肉眼难以察觉异常,等到后期,菌丝会侵入伤口部位,形成类似灰白色绒毛的菌丝体,这种现象多见于水温较低的环境

流行性溃疡是一种由真菌引起的疾病,鱼体表面会出现红色斑点,后来会在体表形成面积较大的“溃疡”。无论是野生的还是养殖的淡水鱼和半咸水鱼,在低温和降雨之后都容易感染这种病。
4.寄生虫性皮肤病
寄生虫性皮肤病存在两种类型,第一种是寄生虫在鱼类体表各部位寄居,产生包囊,例如碘孢虫和小瓜虫;第二种是虫体直接依附在鱼类体表,包括茎双血吸虫、嗜子宫线虫、水蛭、锚头蚤以及鱼鲺。
5.其它皮肤病

单胞藻中的淀粉卵甲藻会导致鱼出现“打粉病”;鱼体弯曲、体色偏浅、体表出血、贫血等症状,是缺少部分微量元素和维生素造成的。
3 鱼类皮肤病的防控
1.预防
坚持预防优先、治理兼顾的方针,管理水域状况、致病因素和鱼体健康这三者的联系,让它们形成最理想的状态,以此来降低鱼儿出现皮病的概率。
(1)调控水环境
控制水域里各种环境条件,包括水温高低、氧气多少、酸碱程度、氨氮含量和亚硝酸盐水平等;时常增加营养、适度更换水体,运用有益微生物,强化水质管理,使水质达到丰饶、灵动、鲜嫩、清爽的状态,改善养殖鱼类的生存条件,保证养殖场所一直维持在最佳状况。
(2)控制和消灭病原体
池塘需要全面清理并进行消毒处理,鱼苗在放入池塘前必须经过浸泡消毒,养殖用的池塘和工具要严格消毒并充分晾晒,养殖期间要尽量减少人为操作导致鱼体受伤,要降低各种应激因素,比如水温剧烈变化、药物刺激等,以防止鱼体受到应激性伤害,还要定时使用二氧化氯、硫酸铜对水体进行消毒和杀虫。
(3)增强鱼体免疫力
选育能够抵抗病害的优良品系,依据鱼类的成长发育对养分的需要,供给相匹配的养料,使营养均衡,实施免疫疫苗的接种,运用免疫多糖、细菌多肽等药品进行免疫防范,选择恰当的喂食方法与喂食规划。
2.治疗
鱼病医治要遵循“紧急时先治表面症状,不急时再治根本原因”的思路。在鱼类容易生病的时段,依照它们的生病特点,定时喂食大蒜素、维生素等药品来预防。控制好养殖的鱼数量,让鱼的体质更强壮,同时管理好水质,这是防止鱼生病的根本措施。
(1)病毒性皮肤病
现在还没有有效的措施,患病的鱼需要单独关照,病鱼所在的区域必须进行清洁,死去的鱼要用石灰进行消毒然后埋掉;健康的鱼可以吃吗啡弧、金刚乙胺,还有像板蓝根、大青叶这类能抵抗病毒的中药;鱼身上可以涂抹碘剂、二氧化氯进行消毒;同时喂食多糖、干扰素、细菌多肽等提高鱼的防御能力。
(2)细菌性皮肤病
口服的阿奇霉素类药物,同中草药制剂,外用二氧化氯溶液、戊二醛制剂、溴氯海因溶液等消毒措施。条件允许时,要实施细菌分离培养,依照药物敏感试验的反馈,挑选效果更佳的药品。
(3)真菌性皮肤病
百分之一氯化钠与百分之零点四碳酸氢钠溶液混合,进行药浴二十分钟,每日执行一次;水体需采用五倍子或硫醚沙星实施消毒操作;将水温调升至二十六度,患病鱼可自行恢复健康。使用二十五克每立方米的壳聚糖对受伤的草鱼进行浸泡,水霉的感染情况得以减轻。
(4)寄生虫性皮肤病
当前针对带有孢子囊的孢子虫和小瓜虫,还没有行之有效的疗法,需要根据其生活周期,在它们对药物较为敏感的幼小发育期,选用适宜的药剂实施浸浴或者喷洒;施药之后进行大量的换水,能够取得一定效果。对于茎双血吸虫、嗜子宫线虫、水蛭、锚头蚤、鱼鲺这类寄生在鱼体表面的害虫,可以使用敌百虫、氯氰菊酯、甲醛等化学药物进行治理。
(5)鱼类皮肤溃烂病
鱼体表皮破损病症,不论哪个季节都可能发生,而且医治起来很不容易,针对这种病症的防控必须秉持“事先防备,防患先于治疗”的方针。鱼儿皮肤一旦出现破损,处理此类状况需同时进行两方面工作,首先要在水中消除有害微生物,其次要针对破损部位进行杀菌,并且配合口服抗生素以清除身体内部的病菌,目前用于外部消毒的药剂主要有含氯成分、含碘成分、季铵盐成分以及过氧化物成分,但这些药剂都易溶于水,难以渗透,只能消灭皮肤表层上的细菌,无法深入腐烂组织发挥杀菌效果。

市面上普遍的硫醚沙星能够克服普通消毒剂的局限,这种物质渗透力非常强,不仅对于细菌有显著的消灭效果,同时对于真菌也表现出优异的控制能力,并且没有毒性也不会留下残留,属于新一代的环保健康药品。所以,在应对各种鱼类皮肤破损感染的情况时,通常可以选用外敷二氧化氯配合硫醚沙星,再配合口服恩诺沙星或诺氟沙星的方式来治疗,能够得到比较理想的治疗成效。
西南渔业网提供配图,文章内容主要参考了当代水产杂志,由陈修松、李雪梅以及邹金虎撰写的文章,在此表示感谢。